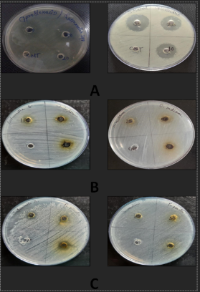

Pharmacological Evaluation of Antioxidant and Antimicrobial Activities of Hydroalcoholic Extracts from <I>Oroxylum Indicum</I> and <I>Pongamia Pinnata</I>
DOI:
https://doi.org/10.71637/tnhj.v25i3.940Keywords:
Oroxylum indicum, Pongamia pinnata, antioxidant activity, DPPH, nitric oxide, hydrogen peroxide, antimicrobial activity, Salmonella bongori, Streptococcus mutans, percentage yieldAbstract
Background: For centuries, plants like Pongamia pinnata and Oroxylum indicum have been recognized in Ayurveda for their medicinal value. Pharmacological studies are essential to validate their traditional therapeutic uses.
Method: This work investigates the antioxidant and antimicrobial activities of hydroalcoholic extracts from Oroxylum indicum and Pongamia pinnata. Antioxidant potential was tested using multiple assays, while antimicrobial effects against Salmonella bongori and Streptococcus mutans were assessed by agar well diffusion.
Result: The extraction yield was 3.59% for Pongamia pinnata and 4.15% for Oroxylum indicum. In the DPPH assay, Oroxylum indicum showed an IC50 of 82.67 μg/ml, indicating stronger radical scavenging compared to Pongamia pinnata (102.62 μg/ml). The nitric oxide assay also favored Oroxylum indicum (82.25 μg/ml) over Pongamia pinnata (106.17 μg/ml). Similarly, in the hydrogen peroxide assay, Oroxylum indicum (76.58 μg/ml) proved more effective than Pongamia pinnata (103.04 μg/ml). Oroxylum indicum exhibited inhibition zones of 14 mm against Salmonella bongori and 14 mm against Streptococcus mutans at 100 mg/ml, whereas Pongamia pinnata showed 12.3 mm and 11 mm, respectively. Ciprofloxacin and Ofloxacin were used as standards, with Ciprofloxacin showing a maximum inhibition zone of 25mm against Salmonella bongori.
Conclusion: Both plants demonstrated antioxidant and antimicrobial potential, with Oroxylum indicum exhibiting greater efficacy than Pongamia pinnata.
Downloads
References
Aware CB, Patil DN, Suryawanshi SS, Mali PR, Rane MR, Gurav RG, Jadhav JP. Natural bioactive products as promising therapeutics: A review of natural product-based drug development. South African Journal of Botany. 2022 Dec 1;151:512-28. https://doi.org/10.1016/j.sajb.2022.05.028
Bholane A, Hiremath VV. A critical review on Karanja (Pongamiapinnata) & its medicinal properties. Journal of Ayurveda and integrated medical sciences. 2020 Apr 30;5(02):194-202.10.21760/JAIMS.V5I02.885
Joshi N, Nailwal TK, Dutta S. Efficient protocol for micropropagation of medicinal forest tree Shyonak (Oroxylumindicum) by silver nitrate promoted high frequency shoot proliferation. Plant Science Today. 2024 Apr 1;11(2). https://doi.org/10.14719/pst.2858
Jagetia GC. A Review on the medicinal and pharmacological properties of traditional ethnomedicinal plant sonapatha, Oroxylumindicum. Sinusitis. 2021 May 25;5(1):71-89.https://doi.org/10.3390/sinusitis5010009
Fugare AG, Shete RV, Adak VS. A review on Pongamiapinnata (L.): traditional uses, phytochemistry and pharmacological properties. Journal of Drug Delivery and Therapeutics. 2021 Feb 15;11(1-s):207-11. https://doi.org/10.22270/jddt.v11i1-s.4522
Chowdhary Y. Chemical composition of Oroxylumindicum: A review. Asian Journal of Pharmacy and Technology. 2021;11(4):296-300.10.52711/2231-5713.2021.00050
Rhee C, Kadri SS, Dekker JP, Danner RL, Chen HC, Fram D, Zhang F, Wang R, Klompas M, CDC Prevention Epicenters Program. Prevalence of antibiotic-resistant pathogens in culture-proven sepsis and outcomes associated with inadequate and broad-spectrum empiric antibiotic use. JAMA network open. 2020 Apr 1;3(4):e202899-. 10.1001/jamanetworkopen.2020.2899
Nurhaslina CR, Bacho SA, Mustapa AN. Review on drying methods for herbal plants. Materials Today: Proceedings. 2022 Jan 1;63:S122-39.https://doi.org/10.1016/j.matpr.2022.02.052
Ibeabuchi JC, Bede NE, Kabuo NO, Uzoukwu AE, Eluchie CN, Ofoedu CE. Proximate composition, functional properties and oil characterization of “Kpaakpa”(Hildergardiabarteri) seed. Research Journal of Food Science and Nutrition. 2020 Feb;5(1):16-29.https://doi.org/10.31248/RJFSN2019.079
Tambun R, Alexander V, Ginting Y. Performance comparison of maceration method, soxhletation method, and microwave-assisted extraction in extracting active compounds from soursop leaves (Annonamuricata): A review. InIOP Conference Series: Materials Science and Engineering 2021 Mar 1 (Vol. 1122, No. 1, p. 012095). IOP Publishing.10.1088/1757-899X/1122/1/012095
Oreopoulou A, Goussias G, Tsimogiannis D, Oreopoulou V. Hydro-alcoholic extraction kinetics of phenolics from oregano: Optimization of the extraction parameters. Food and Bioproducts Processing. 2020 Sep 1;123:378-89.https://doi.org/10.1016/j.fbp.2020.07.017
Munteanu IG, Apetrei C. Analytical methods used in determining antioxidant activity: A review. International journal of molecular sciences. 2021 Mar 25;22(7): 3380.https://doi.org/10.3390/ijms22073380
Tenuta MC, Deguin B, Loizzo MR, Dugay A, Acquaviva R, Malfa GA, Bonesi M, Bouzidi C, Tundis R. Contribution of flavonoids and iridoids to the hypoglycaemic, antioxidant, and nitric oxide (NO) inhibitory activities of Arbutus unedo L. Antioxidants. 2020 Feb 22;9(2): 184.https://doi.org/10.3390/antiox9020184
Mane V, Killedar S, More H, Salunkhe S, Tare H. Development and Validation of a Novel Bioanalytical Method for Estimating Epigallocatechin 3 Gallate in Wistar Rat Plasma by RP-HPLC Employing Gradient Elution Techniques. Journal of Research in Pharmacy. 2023 May 1;27(3):1039. https://doi.org/10.29228/jrp.397
Aggarwal A, Sharma L, Sharma D, Dhobale S, Deshmukh N, Barde L, Tare H. Nutritional Significance of Benincasa hispida. International Journal of Pharmaceutical Quality Assurance. 2023;14(2):410-415. https://doi.org/10.25258/ijpqa.14.2.28
Mane VA, Killedar SU, More HA, Gaikwad AS, Tare HA. A novel RP-HPLC gradient elution technique for bioanalytical method development and validation for estimating gallic acid in wistar rat plasma. Int J App Pharm. 2023 Mar 7;15(2):153-60.
https://dx.doi.org/10.22159/ijap.2023v15i2.47278
Sroka Z, Cisowski WH. Hydrogen peroxide scavenging, antioxidant and anti-radical activity of some phenolic acids. Food and Chemical Toxicology. 2003 Jun 1;41(6):753-8. https://doi.org/10.1016/S0278-6915(02)00329-0
Hajare P, Rai V, Nipate S, Balap A, Pimple B, Chumbhale D, Gaikwad A, Tare H. Anti-arthritic potential of ethyl acetate fraction of Pinus roxburghii Sargent stem bark in Freund's complete adjuvant induced arthritis in Wistar rats. Multidisciplinary Science Journal. 2023 Jun 7;5(4):2023046. https://doi.org/10.31893/multiscience.2023046
Gondru R, Kanugala S, Raj S, Kumar CG, Pasupuleti M, Banothu J, Bavantula R. 1, 2, 3-triazole-thiazole hybrids: Synthesis, in vitro antimicrobial activity and antibiofilm studies. Bioorganic &Medicinal Chemistry Letters. 2021 Feb 1; 33:127746. https://doi.org/10.1016/j.bmcl.2020.127746
Published
Issue
Section
License
Copyright (c) 2025 Sujit Trimbak Karpe, Anil Vishwanath Chandewar, Nitin Indarchandji Kochar, Abhijit Vitthalrao Shrirao

This work is licensed under a Creative Commons Attribution-NonCommercial-ShareAlike 4.0 International License.
The Journal is owned, published and copyrighted by the Nigerian Medical Association, River state Branch. The copyright of papers published are vested in the journal and the publisher. In line with our open access policy and the Creative Commons Attribution License policy authors are allowed to share their work with an acknowledgement of the work's authorship and initial publication in this journal.
This is an open access journal which means that all content is freely available without charge to the user or his/her institution. Users are allowed to read, download, copy, distribute, print, search, or link to the full texts of the articles in this journal without asking prior permission from the publisher or the author.
The use of general descriptive names, trade names, trademarks, and so forth in this publication, even if not specifically identified, does not imply that these names are not protected by the relevant laws and regulations. While the advice and information in this journal are believed to be true and accurate on the date of its going to press, neither the authors, the editors, nor the publisher can accept any legal responsibility for any errors or omissions that may be made. The publisher makes no warranty, express or implied, with respect to the material contained herein.
TNHJ also supports open access archiving of articles published in the journal after three months of publication. Authors are permitted and encouraged to post their work online (e.g, in institutional repositories or on their website) within the stated period, as it can lead to productive exchanges, as well as earlier and greater citation of published work (See The Effect of Open Access). All requests for permission for open access archiving outside this period should be sent to the editor via email to editor@tnhjph.com.